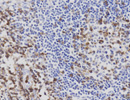
CD43

CD (Cluster of differentiation)
最終更新日:2026.5.12
We are not selling antibodies. / Nous ne vendons pas d'anticorps. / Wir verkaufen keinen Antikorper.
No vendemos un anticuerpo. / 我們沒銷售抗體 / мы не продавать антило.
抗体は販売していません。
| Anti- | CD番号 | 別 名 | HOST | CLONE名 | 適用 |
|---|---|---|---|---|---|
| Human | CD1a | T6,HTA-1 | Mouse | MTB1 | P* |
| Human | CD3 | T3 | Mouse | LN10 | P* |
| Human | CD4 | T4,Helper/Inducer | Mouse | 4B12 | P* |
| Mouse | CD4 | T4,Helper/Inducer | Rabbit | EPR19514 | P* |
| Human | CD5 | T1,Leu-1,panT,BCLL,p67,CD72R | Mouse | 4C7 | P* |
| Human | CD8 | T8,suppressor/cytotoxic | Mouse | 1A5 | P* |
| Mouse | CD8 α | T8,suppressor/cytotoxic, Alpha chain | Rabbit | EPR20305 | P* |
| Human | CD10 | →CALLA,commonALL,Neutral endopeptidase(NEP) | Mouse | 56C6 | P* |
| Human | CD14 | MY4 | Rabbit | EPR3653 | P* |
| Human | CD15 | X-hapten,3-FAL,LewisX,Lex,LNFIII,SSEA-1 | Mouse | Carb-3 | P* |
| Human | CD19 | B4 | Mouse | LE-CD19 | P* |
| Human | CD20cy | →L26,SL26,panB,B1 | Mouse | L26 | P |
| Human | CD21 | →CR2,C3d receptor, SLEB9, | Mouse | 2G9 | P* |
| Human | CD22 | BL-CAM(B lymphocyte cell adhesion molecule),Siglec-2 | Mouse | FPC1 | P* |
| Human | CD23 | IgE-Fc receptor II (FcεRII, FCER2),,blast-2,FCE2,CLEC4J | Mouse | 1B12 | P* |
| Human | CD28 | IgSF,T44,Tp44 | Mouse | CD28.2 | F |
| Human | CD29 | →Integrinβ1 chain,VLA-β,gpIIa | Mouse | 7F10 | P |
| Human | CD30 | →Ki-1,Ber-H2,NGFR-SF | Mouse | Ber-H2 | P |
| Human | CD31 | →PECAM-1 | Mouse | JC70A | P* |
| Mouse | CD31 | →PECAM-1 | Rat | SZ31 | P* |
| Human | CD34 | Multipotent stem cell marker,ICH-3 | Mouse | QBEnd/10 | P |
| Human | CD35 | C3b receptor,→CR1 | Rabbit | EPR6602 | P* |
| Human | CD38 | cADPr hydrolase 1(EC 3.2.2.5),T10 | Mouse | SPC32 | P* |
| Human | CD43 | MT-1,Leukosialin,Sialophorin,gpL115,Galactoglycoprotein(GALGP) | Mouse | MT1 | P |
| Human | CD44 | →HCAM,Hyalronate receptor,Pgp-1(Phagocytic glycoprotein),Hermes,ECMRIII | Rabbit | poly | P* |
| Human | CD45 | →LCA(Leucocyte common antigen),T200,B220,BMAC-1,ly-5(EC 3.1.3.48) | Mouse | X16/99 | P |
| Human | CD45RO | →UCHL-1,p180 | Mouse | UCHL-1 | P |
| Human | |||||
| Human | CD56 | →NCAM-1,Leu-19,NKH-1 | Mouse | 123C3.D5 | P* |
| Human | CD57 | →Leu-7,HNK-1 | Mouse | NK-1 | P |
| Human | CD61 | →Integrinβ3,Platelet gpIIIa,VLAβ3,Vitronectin receptorβ | Mouse | 2f2 | P* |
| → |
|||||
| Human | CD66ce | →CEA,NCA | Rabbit | Poly | P |
| Human | CD68 | →KP-1,macrosialin | Mouse | Kp-1 | P |
| Human | CD79a | CD79A, MB-1 protein, Ig alpha | Mouse | 11E3 | P* |
| Human | CD81 | TAPA-1(Target of anti-proliferative antibody),Tetraspanin-28 | Rabbit | poly | P* |
| Human | CD83 | B-cell activation protein,HB15,Dendric cell marker | Mouse | 1H4b | P* |
| Human | CD95 | →Fas,APO1 | Rabbit | Poly | P |
| Human | CD99 | →MIC2,E2/MIC2,12E7,FMC29,Huly-m6 | Rabbit | EPR3097Y | P* |
| Human | CD105 | →Endoglin | Rabbit | EP274 | P* |
| Human | CD117 | →c-kit,→SCF legand,SCFR | Rabbit | Poly | P |
| Human | CD138 | →Syndecan-1 | Mouse | B-A38 | P* |
| Human | CD140a | →PDGFR α (EC2.7.10.1) | Rabbit | Poly | P |
| Human | CD140b | →PDGFR β (EC2.7.10.1) | Rabbit | Poly | P |
| Human | CD141 | →Thrombomodulin | Rabbit | EPR4051 | P* |
| Human | CD163 | Scavenger receptor cysteine-rich type 1 | Mouse | 10D6 | P* |
| → |
|||||
| Human | CD206 | Macrophage mannose receptor(MMR), CLEC13D, MRC1 | Rabbit | Poly | P* |
| Human | CD235a | →Glycophorin A, sialoglycoprotein α | Mouse | JC159 | P |
| Human | CD246 | →Anaplastic lymphoma kinas(ALK) →p80 NPM/ALK | Mouse | 5A4 | P* |
| Hu,Mo,Ra | CD254 | →RANKL,ODF,OPGL,TRANCE,TNFSF11 | Rabbit | Poly | F |
| Human | CD274 | →PD-L1, B7-H1 | Rabbit | Poly | P* |
What is CD ?
Cluster of Differentiationの略。1970〜80年代頃から主に細胞表面抗原に対し特異的に反応する抗体を用いて白血球など各種の細胞を鑑別同定しようという試みがなされた結果、膨大な数のモノクローナル抗体が世に出ることとなったが、作成者が各自で抗体の名称を付けていた。
その混乱と煩雑性を防ぐために国際的なワークショップ(International Workshop on Human Leucocyte Differention Antigen:第1回会議は1982, パリ)が開かれ、それぞれの認識する抗原ごとに抗体を区分し、CD分類として順に番号を付けたのが始まり。その後、白血球だけでなく内皮細胞や線維芽細胞などにも対象が拡大され、第10回会議では370種にも分類されている。(ちなみに神戸でも1回開催されている)こういうように抗体を分類することは便利な面も多いが、あくまでも分類であって、例えば「CD20」に分類される抗体がすべて「同じもの」=認識する抗原基が同一とは言えないことには注意しておく必要がある。 また、一度国際的に決定されて広まってしまうと後から変更するのは困難になってくるため、既にひとつのCD番号で決定されたものが実は複数の分子からなる抗原群を認識していたことが判明した場合には、例えば「CD49a」「CD49b」のようにCD番号の後ろに小文字のアルファベット記号を付けて細分類する必要が出てくる。 そして、例えばLFA-1のα鎖はCD11a、β鎖はCD18と分類された結果、LFA-1というひとつの機能分子に対してCD11a/CD18と表現せざるを得ないようなことにもなっている。 ちなみに、CD番号の後ろには他にも何かと文字記号が付けられることがある。例えば、CD45などはスプライシングによってエクソンの異なる複数種があり、「RA」や「RB」のように「R」(Restricted=制限、限定)を付けて区別されている。 CD62は、もともとのSelectinとしての分類に準じて、E(Endothel), L(Leucocyte), P(Platlet)などが付記されている。他にもシアル化しているから「s」とか、バリアントのひとつだから「v」とか、本来はもっとシンプルだったのでしょうが、CD番号を抗体分子名の如く扱うことによるややこしさもみられる。極めつけは「w」(Workshopの頭文字)かもしれません。 |
膜貫通蛋白
CDは膜表面抗原が多く、膜貫通蛋白という言葉が説明中によく出てきます。「膜貫通蛋白」とはN末端〜C末端に至るアミノ酸配列がちょうど髪の毛のように細胞膜を貫いて細胞内から細胞外に突き出している構造をもつもので、そのうち「 I 型」とはN末端側が、「II 型」とはC末端側が細胞外に突き出している構造のものです。
(つまり逆向きになっている)他に糸で縫ったように4回細胞から出たり入ったりしている4回膜貫通型というのもあります。また、これらには糖鎖を結合するものも多く、中にはそれ自体は細胞膜を貫通していなくて糖鎖を錨(アンカー)の様に細胞膜に引っ掛けて細胞表面にくっ付いている蛋白(GPIアンカー型)もあります。これは膜蛋白ではありますが「膜貫通型」とは言いません。 |
| CD1a | ||
|---|---|---|
![]() CD1a X400 |
327aa, 約40kDaほど(糖鎖が結合して修飾される)の細胞膜貫通型の糖蛋白(Gene:1q 22-23)。細胞外領域にα1〜α3のドメインがあり、α3にβ2-microglobulinが非共有結合する。 Langerhans細胞、樹状細胞の一部、胸腺皮質細胞に発現するほか、サイトカインで刺激した単球に誘導される。clone:O10はホルマリン固定パラフィン切片でも熱処理で反応。
|
|
![]() CD2 X400 |
1p 13.1,351aa,45-58kDa(糖鎖修飾)の糖蛋白。LFA-3レセプター(ヒツジ赤血球受容体)であり、T細胞と抗原提示細胞・標的細胞との接着に関与するI型膜貫通蛋白。細胞質内ドメインはシグナル伝達にも関与する。別名:LFA-2,LFA-3 receptor,SRBC(sheep red blood cell receptor)ホルマリン固定パラフィン切片では要熱処理。(リストより削除しました。)
|
|
| CD3 | ||
|---|---|---|
![]() CD3 X400 |
CD3(11q 23.3)には γ(182aa)、δ(171aa)、ε(207aa)、ζ(164aa,CD247)の各鎖があり(η鎖はヒトでは解明されていない。またζ鎖はCD3とは別に扱われることもある)、γεまたはδεのヘテロダイマーがT細胞抗原レセプター(TCR)αおよびβ鎖と結合(ζは別に結合)してTCR-CD3複合体を形成する。
CD3と呼ばれる市販抗体はε鎖を認識するものが通常多い。ホルマリン固定パラフィン切片では要熱処理。
|
|
| CD4 | ||
|---|---|---|
![]() CD4 Human LN X400 ![]() CD4 Mouse LN X400 |
T細胞のサブセット(helper/inducer)表面に発現する12p 13.3,458aa,約59kDaの糖蛋白。T細胞上のTCR-CD3複合体と抗原提示細胞のMHC class II分子との結合を補助する。ホルマリン固定:要熱処理、過酸化水素による内因性Pox活性のブロック処理は抗原エピトープに強く影響するので、例え一般的protocolに対応できるというclone:4B12であっても過酸化水素濃度を0.5%以下に下げるか、一次抗体反応後に行う方が賢明。
|
|
| CD5 | ||
|---|---|---|
![]() CD5 X400 |
11q 12.2,495aa,約67kDaの糖蛋白で I 型膜貫通蛋白、リガンドはCD72。T細胞にあってはリガンドと結合してIL-2,IL-2R発現を増強しT細胞の増殖を促すので「T細胞マーカー」と言われることもあるが、B細胞の一部(B1a)にも発現しB細胞レセプター(BCR)刺激を抑制的に調節しているらしい。
ホルマリン固定:要熱処理(EDTAの方が強い)
|
|
![]() CD7 X400 |
17q 25.2-25.3,240aa,約40kDa,別名:GP40,TP41(Tp40)とも呼ばれる糖蛋白で I 型膜貫通蛋白。機能的にはまだ充分明らかになっていないがT細胞分化の初期段階で発現すると言われる。ホルマリン固定:要熱処理 (リストより削除しました。)
|
|
| CD8 | ||
|---|---|---|
![]() CD8 Human LN X400 ![]() CD8 Mouse LN X400 |
α(2p 12,235aa)とβ鎖(2p 12,210aa)のヘテロダイマーからなる糖蛋白で、T細胞サブセット(cytotoxic/suppressor)および胸腺細胞、NK細胞の一部などの表面の I 型膜貫通蛋白。T細胞表面のTCR-CD3複合体と抗原提示細胞の MHC class I 分子との結合を補助するとともに刺激を抑制的に調節する。ホルマリン固定:要熱処理
|
|
![]() CD9 X400 |
12p 13.31,227aa,22-27kDa,別名:Tetraspanin(TSPAN)-29,MIC3,Motility-related protein(MRP-1),DRAP27,p24などとも呼ばれる4回膜貫通ドメインをもつ糖蛋白。EWI-2と複合体を形成し血小板の活性・粘着や細胞接着の調節、シグナル伝達等に関与し、血小板α顆粒、単球、好塩基球、好酸球、pre-B細胞、活性T細胞や上皮細胞等も含めて幅広い細胞に分布する。
(削除)
|
|
| CD10 | ||
|---|---|---|
![]() CD10 X400 ![]() CD10 小腸 X400 ![]() CD10 子宮体部 X400 |
3q 25.1-25.2,749aa ,90-110kDa(糖鎖を含む),別名:Neutral endopeptidase(NEP)、Neprilysin、Common acute lymphocytic leukemia antigen(CALLA)。好中球、リンパ球前駆細胞、リンパ濾胞内の活性化B細胞に発現する II 型膜貫通蛋白。亜鉛結合酵素(EC 3.4.24.11)で、エンセファリン、サブスタンスPなどの炎症物質を分解する。
腎尿細管・小腸粘膜(刷子縁)・気管支粘膜上皮等にも発現しており腎細胞癌、子宮内膜間質肉腫など様々な非血液腫瘍で陽性という。(診断病理&免疫組織化学総合データベース「immu〜no」) また、高異型度でCD10を発現する大腸癌は肝転移リスクが高いという報告もある。(下田忠和:2003厚労省がん研究助成研究) ホルマリン固定:要熱処理
|
|
![]() CD11 X400 |
16p 11-13,1170aa,約180kDa → 【L】 LFA-1 → 【 I 】 Integrin αL (現在、リスト非掲載です) |
![]() CD11b X400 |
16p11-13,1152aa,約170kDa → 【M】 Mac-1 → 【 I 】 Integrin αM (現在、リスト非掲載です) |
![]() CD11c X400 |
16p 11.2,1163aa,約150kDa → 【 I 】 Integrin αX
(現在、リスト非掲載です) |
| CD14 | ||
|---|---|---|
![]() CD14 X400 |
5q 31.1,375aa,53-55kDaの糖蛋白のC末端側のGlycosyl phosphatidyl inositol(GPI)アンカーと呼ばれる部分で、主に単球・マクロファージなどの細胞膜に結合しているほか好中球にも弱く発現している。N末端側がリポ多糖類(LPS)受容体複合体の一部となり、IL-1、TNFα産生を刺激する。GPIアンカーを欠くものは可溶性蛋白として血中に存在する。
|
|
| CD15 | |
|---|---|
![]() CD15 X400 |
ルイス式血液型物質の Lewis X(Lex)にあたる糖鎖抗原で、X-haptenとも呼ばれる。N-acetylglucosamine(GlcNAc)にGal(β1,4)とFuc(α1,3)が結合しており、Lewis A(Galβ1-3GlcNAc,Fucα1-4GlcNAc)と似ているが結合部位が異なる。またシアル酸(NeuAc)が結合するとCD15sとなる。骨髄系細胞の初期分化段階から発現し、好中球・好酸球・単球などの細胞表面の糖蛋白や糖脂質に含まれる。また Hodgkin病ではReed-Sternberg細胞の細胞膜および細胞質の一部(ゴルジ野)が陽性となり、T lymphomaの一部や上皮細胞の一部も反応する。
|
![]() CD15s X400 |
→ 【S】 Sialyl Lewis X (現在、リスト非掲載です) |
![]() CD16 X400 |
低親和性IgG Fcレセプター(Low affinity immunoglobulin gamma Fc region receptor III :FcγRIII,FcR-10)で、α(FcγRIIIA,1q23,254aa,50-65kDa,膜貫通型)とβ(FcγRIIIB,1q23,233aa,48kDa,GPIアンカー型)のisoformがあり、前者はnatural killer(NK)細胞、マクロファージ、T細胞の一部、胎盤絨毛などに、後者は好中球、好酸球などに発現する。
(リストより削除しました)
|
|
21q 22.3,747aa → 【 I 】 Integrin, β2 subunit
(現在、リスト非掲載です)
|
||
| CD19 | ||
|---|---|---|
![]() CD19 X400 |
16p 11.2,556aa,約61kDa,形質細胞を除くB細胞系に幅広く発現しB4とも呼ばれるIg super familyに属する I 型膜貫通性糖蛋白で、濾胞樹状細胞(FDC)にも発現する。細胞質内ドメインにチロシンキナーゼを有する一方、sIgを介してCD21(CR2)やCD81と複合体を形成し、抗原刺激によるシグナル伝達に関与する。
(御希望により復活しました。しかも今度はFFPE対応抗体です。)
|
|
| CD20( | |
|---|---|
![]() CD20cy X100 |
比較的広範囲なB細胞表面に発現する4つの膜貫通ドメインを持った膜貫通型蛋白。細胞質内領域のリン酸化の違いによる33,35,37kDの3種類のisotypeがある。ホルマリン固定・パラフィン切片でも反応する(厳密には弱いこともあるが)抗体として長く重宝されてきたclone:L26は細胞質内領域をエピトープとするため「CD20cy」と呼ばれ、膜表面だけでなく細胞質に反応する。clone:7D1など他のCD20抗体で細胞外領域をエピトープとする(膜に近い部分を認識することが多い)ものでは細胞膜に反応する。 |
| CD21 | ||
|---|---|---|
CD21 X400 |
1q 32,1033aa,145kDa → 【C】Complement receptor type 2 (CR2)
|
|
| CD22 | ||
|---|---|---|
![]() CD22 X400 |
19q 13.1,847aa,Ig super familyに属する I 型膜貫通糖蛋白で、α(約130kDa)とβ(約140kDa)のisoformがある。細胞外ドメインでシアル酸含有糖鎖(NeuGc)と結合するIタイプレクチンとしてsialic acid-binding immunoglobulin-like lectin-2 (Siglec-2)と呼ばれる。また形質細胞を除くB細胞系に広く発現し、B lymphocyte cell adhesion molecule(BL-CAM)とも呼ばれ、IgM,IgD型B細胞受容体(BCR)の抗原刺激を抑制的に調節する。
|
|
| CD23 | ||
|---|---|---|
![]() CD23 X400 |
19p 13.3,321aa,45-50kDaのCタイプ動物性レクチンに属する糖蛋白でC-type lectin domain family 4, member J (CLEC4J)とも呼ばれる。細胞表面のIgE Fcレセプター(FcεR)のひとつで、Low affinity immunoglobulin epsilon Fc receptor(FcεRII, FCER2)とも呼ばれる。FcεR には好塩基球や Mast cellに発現しIgEに親和性が高い FcεRIと、別のリガンド(CD21)を持つため親和性の低い FcεRII(CD23)とがある。
CD23にはB細胞の分化抗原として濾胞細胞などに発現するCD23aと、IL-4によりB細胞はじめT細胞、好酸球、単球、Macrophageなどに発現誘導されるCD23bとがある。蛋白分解酵素により切断され可溶性になりやすい。
|
|
![]() CD24 X400 |
6q 21の遺伝子にコードされるGPIアンカー型の膜糖蛋白で、形質細胞を除くB細胞表面に広く発現してその活性を調節しているほか、マクロファージによる貪食を回避するための「Don't eat me」シグナルのひとつとして腫瘍細胞でも発現がみられ、
Small cell lung carcinoma Cluster 4とかHeat stable antigenとも呼ばれる。
CD24のコアペプチド自体はアミノ酸残基30個程度とされる小型の蛋白であるが、付加される糖鎖による修飾が強いため、データベースによって分子量やアミノ酸長に違いがある。
基本、細胞膜に陽性だが細胞質にびまん性あるいはドット状に染まることもある。
(現在、リスト非掲載です)
|
|
![]() CD25 X400 |
10p 15,272aa,約55kDa → 【 I 】 IL-2R α chain
(現在、リスト非掲載です)
|
|
| CD28 | ||
|---|---|---|
2q 33,202aa(前駆体として約25kDa)の鎖が2量体を形成。別名:T cell specific surface glycoprotein TP44,KOLT2とも呼ばれ、T細胞表面に恒常的に発現する免疫グロブリンsuper familyに属する I 型膜貫通蛋白。リガンドは CD80(B7-1,BB1)と CD86(B7-2)で、これらとの結合により抗原提示細胞からの刺激を伝達し Ras経路の刺激、IL-2などのサイトカイン・ケモカイン産生増強、Apoptosisの抑制などの効果を与える。構造の似た CD152(CTLA4)とリガンドが共通している。
|
||
| CD29 | ||
|---|---|---|
![]() CD29 X400 |
10p 11.2,778aa → 【 I 】 Integrin, β1 subunit
|
|
| CD30 | ||
|---|---|---|
![]() CD30 X400 |
1p 36,595aa,約120kDa → 【K】 Ki-1
|
|
| CD31 (for human / for mouse) | ||
|---|---|---|
![]() CD31 X400 |
17q 23,738aa,約130kDa → 【P】 PECAM-1
|
|
![]() CD33 X400 |
19q 13.3,364aa,Sialic acid binding Ig-like lectin-3 (Siglec-3)とも呼ばれるレクチン構造を含む I 型膜貫通蛋白で、接着およびシグナル伝達関連分子として骨髄単球系細胞・マクロファージおよびNK細胞などに発現する糖蛋白。(抗体を使用しきったため、リストより削除しました)
|
|
| CD34 | ||
|---|---|---|
![]() CD34 X400 |
1q 32,385aa,105-120kDaの膜貫通型ムチン様糖蛋白。Hematopoietic progenitor cell antigen とも呼ばれ未分化な造血幹細胞、比較的小型の毛細血管の内皮細胞や未分化な間葉系細胞に発現。
|
|
| CD35 | ||
|---|---|---|
![]() CD35 X400 |
1q 32,2039aa,160-250kDa → 【C】Complement receptor type I (CR1)
|
|
| CD38 | ||
|---|---|---|
![]() CD38 X400 |
300aa,45kDaの II 型膜貫通型蛋白(Gene:4p 15)で、Cyclic ADP-riboseの合成酵素でありながら、その水解酵素(EC:3.2.2.5)活性も示す。幅広い白血球前駆細胞や活性化したT/B細胞、単球、形質細胞などに発現する。B細胞ではごく初期に発現した後、成熟過程で消失し、形質細胞への分化段階で再発現する。多発性骨髄腫の鑑別に利用される。
|
|
![]() CD41 細胞塗抹 X400 |
17q 21.32,1039aa → 【P】 Pletelet glycoprotein IIb → 【 I 】 Integrin,αIIb subunit (現在、リスト非掲載です) |
17p ter-p12,前駆体として626aa,69kDa。von Willebrand因子の A1ドメインと結合して血小板を凝集させる Platelet glycoprotein Ib(gpIb,GPIb)はα鎖とβ鎖のヘテロダイマーからなる I 型膜貫通蛋白で、CD42bはそのα鎖である。(β鎖はCD42c)
(現在、リスト非掲載です)
|
||
| CD43 | ||
|---|---|---|
![]() CD43 X400 |
400個ほどのアミノ酸と糖鎖からなる95-135kDほどの糖蛋白で、ICAM-1(CD54)のリガンドである T 型膜貫通蛋白(Gene:16p11.2)。80箇所以上もの glycosylation siteを持ち質量の半分以上を糖鎖が占める。T細胞の活性化に関係し、パラフィン切片でも反応する抗体だったのでT細胞の”マーカー”として用いられてきたが、腺上皮や神経系にも発現している。
|
|
| CD44 | ||
|---|---|---|
![]() CD44 X400 |
ヒアルロン酸の受容体である T 型膜貫通蛋白で、Phagocytic glycoprotein(PGP-1)、HUTCH-I、H-CAM、Hermes antigen、Extracellular matrix receptor-III(ECMR-III)などとも呼ばれる。白血球、線維芽細胞ほか様々な細胞に発現し細胞接着に関係する。単一遺伝子(11p13)にコードされるものの選択的スプライシングにより多数のvariantがあり、そのうち主要なCD44Sは742aa,約85kD。ヒアルロン酸結合部分を含むN末端側のアミノ酸90残基ほどは種間保存性が高い。
|
|
![]() CD44v6 X400 |
もっとも一般的に発現しているCD44はCD44standard form(CD44S)とかbasic CD44などと呼ばれ、standard exonと呼ばれる exon1〜5,16〜18,20が選択的に発現しているが、variant exonと呼ばれる exon6〜15が挿入されて生じる変異分子(CD44 variant form:CD44v)が20種類ほど知られており、exon11がスプライシングを受けたv6は進行性大腸癌で強く発現することが報告されている。
(※ exon6挿入による変異分子は v6ではなく v1になる。また蛋白分解酵素で切断されやすく膜結合性を失い可溶型となったものをsCD44というので混同しないように。)
(現在、リスト非掲載です) |
| CD45 | |
|---|---|
![]() CD45 X400 |
1q 31-32.1,(Full lengthで1304aa),チロシンフォスファターゼ活性(EC3.1.3.48)をもつ I 型膜貫通蛋白。細胞外領域に多数の糖鎖結合部位をもつ。スプライシングによりN末端側が変化したIsoformが8つ(近時9つとも)存在し、分子量も180〜220kDと幅があり低分子量のものはT細胞に、高分子量のものはB細胞に比較的多く分布する傾向がある。「Leukocyte common antigen(LCA)」とも呼ばれるが、モノクローナル抗体ではcloneにより認識するエピトープに違いがある場合は当然反応が異なることがあり、抗体によっては異なるcloneを混合したCocktail抗体もある。 |
![]() CD45RA X100 |
CD45遺伝子の exon4(A),5(B),6(C)が alternative splicingにより欠失してできる variantの内、exon4(A)を有する分子量220kDのものは CD45RA(gp210/220)と呼ばれ、大半のB細胞、単球、胸線髄質細胞および末梢T細胞の一部(CD4+細胞など)に発現する。B細胞では広汎に発現するのに対して、T細胞では主にnative/virgin Tに発現し、末梢T細胞はCD45RA+CD45RO-とCD45RA-CD45RO+に分けられる。
(2014.4.16 リストより削除しました) |
| CD45RO | |
|---|---|
![]() CD45RO X100 |
CD45遺伝子の選択的スプライシングによって exon4(A),5(B),6(C)の全てを欠く分子量180kDのものは CD45RO(gp180)と呼ばれ(ABO式血液型のO型と同様に本来の意味としてはRO[オー]ではなくR0[ゼロ]になる)、主にT細胞(胸線T、活性化Tなど)、単球・マクロファージ・好中球の一部に発現する。ホルマリン固定パラフィン切片でも反応する(実際には反応が弱いこともある)抗体としてclone:UCHL-1が非常に有名になったため、「UCHL-1」をCD45RO抗原の代名詞的に用いる人もいるが、まったく別の抗原の略号でも使用されているので注意。 |
![]() CD47 肺癌 X400 |
3q 13.12,323aa,約35kDa。免疫グロブリンスーパーファミリーに属し、 インテグリンなどと結合する糖タンパクで Integrin-associated protein (IAP)ともいう。
N末端側の細胞外ドメイン、膜貫通ドメイン、C 末端側の細胞内ドメインからなり、選択的スプライシングによりC 末端の長さが異なる少なくとも4つのアイソフォームがある。
元々はヒト卵巣がんの腫瘍抗原として同定されたらしいが、血管新生の阻害や、マクロファージに対して 「Don't eat me」 signalとして働く。
(現在、リスト非掲載です)
|
|
![]() CD49d X400 |
CD49a(VLA1,α1):5p15-p11, 1151aa → 【 I 】 Integrin α1/β1 CD49b(VLA2,α2):5q23-q31, 1181aa(30-1181:1103aa) → 【 I 】 Integrin α2/β1 CD49d(VLA4,α4):2q31-q32, 1038aa(40-1038:999aa) → 【 I 】 Integrin α4/β1 CD49f(VLA6,α6):2q22-q31, 1030aa(23-1130:1107aa) → 【 I 】 Integrin α6/β1 (現在、リスト非掲載です) |
19p 13.3-13.2,547aa → 【 I 】 ICAM-3
(リストより削除しました)
|
||
![]() CD54 X400 |
19p 13.3-13.2,532aa,76-114kDa → 【 I 】 ICAM-1 (リストより削除しました)
|
|
| CD56 | ||
|---|---|---|
![]() CD56 X400 |
11q 23-24,741aa,120/140kDa → 【N】 NCAM
|
|
| CD57 | |
|---|---|
![]() CD57 X400 |
ヒト細胞株HSB-2を免疫原とする抗体(clone:HNK-1)の認識する糖鎖抗原。末梢神経など神経系の一部、Human natural killer(HNK)細胞などの表面に発現することが知られているほか、毛細血管内皮や内分泌細胞にも発現する。NCAM(CD56)やTenasinなどの糖蛋白の一部や糖脂質に含まれ、L,P-Selectinのリガンドとして働くなど細胞の接着や移動に関わっていると考えられているが具体的な機能はまだ不明。 |
| CD61 | ||
|---|---|---|
![]() CD61 X400 |
17q 21.31,788aa → 【P】 Pletelet glycoprotein IIIa → 【 I 】 Integrin β3
|
|
![]() CD62E X400 |
1q 12,610aa,110kDa → 【S】 E-Selectin、 【M】 Mucin antigens - Lectin
(リスト削除)
|
|
![]() CD62L X400 |
1q 23,372aa,70-120kDa → 【S】 L-Selectin、 【M】 Mucin antigens - Lectin
(リストより削除しました)
|
|
![]() CD62P X400 |
1q 23,830aa,140kDa → 【S】 P-Selectin、 【M】 Mucin antigens - Lectin
(リスト削除)
|
|
| CD66c/CD66e | ||
|---|---|---|
![]() CD66e(CEA) X400 |
Gene:19q 13.2にコードされる CD66c(Non-specific crossreacting antigen あるいは Normal cross reacting antigen:NCA,前駆体として344aa)と CD66e(Carcinoembryonic antigen:CEA,前駆体として702aa)は immunoglobulin superfamily に属する接着分子で CEA familyと呼ばれ、アミノ酸配列のうち下線の部分が相同。→ 【C】 CEA
|
|
| CD68 | ||
|---|---|---|
![]() CD68 X400 |
→ 【K】 Kp-1
|
|
![]() CD69 X400 |
12p13.31, 199aa. 免疫系における早期活性化マーカー。細胞接着分子としての機能もあり血小板にも発現。 (リスト非掲載)
|
|
| CD79a (CD79A) | ||
|---|---|---|
![]() CD79a X400 |
19q 13.2,226aa,約47kDaの糖蛋白。モノマーまたは CD79bとヘテロダイマーを形成して形質細胞を除くB細胞表面に発現しておりMB-1(mb-1)とも呼ばれる。またImmunoglobulin-associated alpha(Ig-α)とも呼ばれ、全クラスのsIgと複合体を形成し抗原刺激のシグナル伝達に関与すると共にsIgの表出に必須のものと考えられている。膜貫通部〜細胞質内領域については種間相同性が高い。
|
|
![]() CD80 Spleen X400 |
3q 13.3-21,288aa,約33kDaの免疫グロブリン様ドメインを有する I 型膜貫通蛋白で多数の糖鎖が付加されている。抗原刺激を受けたB細胞、マクロファージ、樹状細胞など抗原提示細胞の表面に発現しT細胞を活性化する。B7 activation antigen(B7-1,BB1)とも呼ばれる。CD86とともにCD28/CD152のリガンドとして働く。
(抗体切れとなりました)
|
|
| CD81 | ||
|---|---|---|
![]() CD81 X400 |
11p 15.5,236aa,約26kDaの4回膜貫通型蛋白で、CD9と同じTransmembrane 4 super family(TM4SF)に属し、Tetraspanin-28(TSPAN-28)と呼ばれる。Integrinや他のTM4メンバー(CD37,53など)と複合体を形成して細胞の分化、増殖の調整に関わり、細胞の増殖抑制を示すことからTarget of the antiproliferative antibody 1(TAPA-1)とも呼ばれる。HCVに対しco-receptor活性を示すと考えられている。大半のB細胞や一部単球などに発現する。
|
|
| CD83 | ||
|---|---|---|
![]() CD83 X400 |
6p 23,205aa,約23kDa。B-cell activation protein、Cell surface protein HB15とも呼ばれる。免疫グロブリンスーパーファミリーに属する単量体の I 型膜貫通蛋白。Dendric cell,Langerhans cellに発現しB細胞を活性化するほか、Hodgkin病のRS細胞にも陽性。
|
|
![]() CD86 X400 |
3q 33.33,329aa。免疫グロブリンの可変ドメインに似たIg様ドメイン(V-Set doamain)をもつB7 family蛋白のひとつでB7.2とも呼ばれる。CD28LG。
|
|
| CD95 | ||
|---|---|---|
![]() CD95 X400 |
10q 24.1,335aa,約45kDa → 【F】 FAS
|
|
| CD99 | ||
|---|---|---|
![]() CD99 X400 |
Xp 22.32/Yp 11.3,185aa,30/32kDa → 【M】 MIC2 (2012.2.14 cloneを変更しました)
|
|
17q 23-25,275aa → 【 I 】 ICAM-2
(抗体切れにつき現在リスト非掲載です)
|
||
![]() CD103 X400 (回腸 IEL) ![]() CD103 X400 (HCL 脾) |
Integrin αE(17p13.2, ITGAE )とβ7(12q13.13, ITGB7 )の二量体(αEβ7)で、腸管上皮内リンパ球(IEL)や粘膜固有層のリンパ球(T細胞)表面に発現し、上皮細胞間の E-Cadherinと結合する。
Human Mucosal Lymphocyte Antigen 1 (HML-1)とも呼ばれるが、腸管以外の制御性T細胞や樹状細胞でも発現がみられるほか、B細胞由来の白血病であるHCLでも発現がみられる。サブユニットのβ7はα4とも二量体を形成するので、実質的にCD103抗体はαEに対する抗体となる。
(現在リスト非掲載です)
|
|
| CD105 | ||
|---|---|---|
![]() CD105 X400 |
9q 33-34.1,658aa,約180kDa → 【E】 Endoglin
|
|
![]() CD106 X400 |
1p 32-31,739aa ,約80kDa → 【V】 VCAM-1
(現在、リスト非掲載です)
|
|
| CD117 | ||
|---|---|---|
![]() CD117 乳腺 X400 |
4q 11-12,976aa,145-160kDa → 【C】c-kit
|
|
![]() CD124 X400 |
16p 11.2-p12.1,825aa → 【 I 】 Interleukin-4 receptor αchain
(現在、リスト非掲載です)
|
|
| CD138 | ||
|---|---|---|
![]() CD138 X400 |
2p 24.1,293aa,約33kD → 【S】 Syndecan-1
|
|
| CD140a | ||
|---|---|---|
![]() CD140a X400 |
4q 11-13,1089aa,EC 2.7.10.1 → 【P】 PDGFR α
|
|
| CD141 | ||
|---|---|---|
![]() CD141 X400 |
20p 11.2,575aa,約75kDa → 【T】 Thrombomodulin
|
|
![]() CD151 X400 |
11p 15.5,253aa,約30kDaの4回膜貫通型蛋白。CD9、CD81等と同じTransmembrane 4 super family(TM4SF)で、Tetraspanin-24(TSPAN24)と呼ばれる。
Integrinα3β1等と複合体を形成、細胞接着の調節やシグナル伝達、血小板粘着、血管新生等に関係し、Platelet-endothelial cell tetraspan antigen(PETA)-32、GP28/32、MER2、RAPH、SFA1とも呼ばれる。血小板、血管内皮細胞、macrophage、活性化T細胞等のほか、上皮細胞にも種々の程度で発現。
(リスト非掲載です)
|
|
| CD163 | ||
|---|---|---|
![]() CD163 胎盤 X100 ![]() CD163 X400 |
12p 13(7.52-7.55 Mbp),1156aa,約125kDaの1回膜貫通型蛋白。Hemoglobin scavenger receptor,macrophage-associated antigen,Scavenger receptor cysteine-rich type 1 protein,M130とも呼ばれ、Kupffer cells(肝)や赤脾髄、胸線皮質などのmacrophage、monocyte等に発現しており、Ca++およびpH依存性にhemoglobin/haptoglobin複合体と結合、その細胞内処理を促進し、フリーラジカルの処理や鉄のリサイクルに関与。glucocorticoids, IL-6,IL-10などを誘導する。
Iba1やiNOS、CD68, CD206等とともにM1/M2MΦの鑑別にも使用される。
|
|
![]() CD178 X400 |
1q 23,261aa,約30kDa → 【F】 Fas Ligand(現在、リスト非掲載です)
|
|
![]() CD184 X400 |
Gene:2q21,352aa → 【C】 CXCR4 7回膜貫通型G蛋白共役受容体(GPCR)蛋白で、C-X-C chemokine receptor type4(CXCR4)、stromal cell derived factor-1receptor, Neuropeptide Y receptor Y3, Fusin等とも呼ばれる。(現在、リスト非掲載です)
|
|
| CD206 | ||
|---|---|---|
![]() CD68との重染 X200 ![]() F4/80との重染 Mouse X400 |
10p13(mrc-1),1456aa,約166kDaの I 型膜貫通蛋白で、レクチン様の糖鎖認識ドメインを有し、C-Type Lectin Domain Family 13 Member D(CLEC13D)、Mannose receptor C-type 1(MRC1)とも呼ばれる。
活性マクロファージ(MΦ)、未熟な樹状細胞などの表面に発現し、糖蛋白の認識・貪食に関与するほか、内皮細胞にもみられる。Iba1やiNOS、CD68, CD163等との重染色によるM1/M2MΦの識別にも使える。
|
|
![]() CD207 X400 |
2p 13,328aa,約40kDa → 【L】 Langerin
(抗体なくなりました)
|
|
3q27.1 LAMP3, 416aa → Lysosome-associated membrane glycoprotein 3 (LAMP3), Dendritic cell-lysosomal associated membrane protein (DCLAMP)(リスト非掲載)
|
||
| CD235a | ||
|---|---|---|
![]() CD235a X400(X4) |
4q 31.21,150aa,約16kDa → 【G】 Glycophorin A
|
|
| CD246 | ||
|---|---|---|
![]() CD246 X400 ![]() CD246 X400 |
2p23,1620aa,約200kDa → 【P】 Anaplastic lymphoma kinase (ALK),p80
|
|
| CD254 | ||
|---|---|---|
![]() CD254 X400 |
13q 14,317aa,約40kDa → 【R】 RANKL
|
|
| CD273 | ||
|---|---|---|
![]() CD273 X400 |
9p 24.1,273aa,約30kDa → 【P】 PD-L2 , B7-DC
|
|
| CD274 | ||
|---|---|---|
![]() CD274 X400 |
9p 24,290aa,約40kDa → 【P】 PD-L1 , B7-H1
|
|
![]() CD276 X100 |
15q24.1 CD276, 534aa → B7-H3 (リスト非掲載)
|
|
2q33.2: ICOS 199aa → Inducible T cell costimulator (ICOS), Activation-inducible lymphocyte immunomediatory molecule (AILIM), B7-H2 (リスト非掲載)
|
||
![]() CD303 X400 |
12p13.31 CLEC4C, 213aa. →Dendritic lectin (DLEC), C-Type Lectin domain family 4 member C (CLEC4C), Blood dendritic cell antigen 2 (BDCA2) (リスト非掲載)
|
|






















CD21 X400